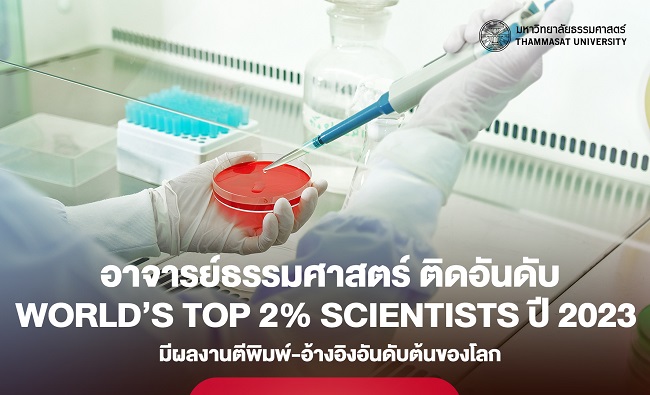

14 นักวิจัยธรรมศาสตร์ ติดอันดับ World’s Top 2% Scientists ปี 2023 มีผลงานตีพิมพ์-อ้างอิงสูง
คณาจารย์นักวิจัยทางวิทยาศาสตร์ของมหาวิทยาลัยธรรมศาสตร์ ติดอันดับ World’s Top 2% Scientists ปี 2023 มีฐานข้อมูลผลงานตีพิมพ์และถูกอ้างอิงอันดับต้นของโลก
วันพฤหัสบดีที่ 12 ตุลาคม พ.ศ.2566
คณาจารย์นักวิจัยทางวิทยาศาสตร์ของมหาวิทยาลัยธรรมศาสตร์ ติดอันดับ World’s Top 2% Scientists ปี 2023 (หรือ A list of top 2 percent of the world scientists) โดยมีฐานข้อมูลผลงานตีพิมพ์และถูกอ้างอิงอันดับต้นของโลก จัดโดย มหาวิทยาลัยสแตนฟอร์ด สหรัฐอเมริกา ทั้งนี้ มีคณาจารย์ของมหาวิทยาลัยธรรมศาสตร์ ติดอันดับรวมทั้งสิ้น 14 ท่าน ดังนี้
ประเภท Career-long data (คิดผลงานตั้งแต่อดีตจนถึงปี ค.ศ. 2022)
1. ศ.ดร.ผดุงศักดิ์ รัตนเดโช จากคณะวิศวกรรมศาสตร์
2. ศ.ดร.จงรักษ์ ผลประเสริฐ จากคณะวิศวกรรมศาสตร์
3. ศ.ดร.สมชาติ ฉันทศิริวรรณ จากคณะวิศวกรรมศาสตร์
4. รศ.ดร.วุฒิพล สินธุนาวารัตน์ จากคณะวิทยาศาสตร์และเทคโนโลยี
5. ศ.ดร.เกศรา ณ บางช้าง จากวิทยาลัยแพทยศาสตร์นานาชาติจุฬาภรณ์
6. Prof. Dr. Kuprianov, Vladimir จากสถาบันเทคโนโลยีนานาชาติสิรินธร
7. Prof. Dr.Sandhya Babel จากสถาบันเทคโนโลยีนานาชาติสิรินธร
8. ศ.ดร.ธนัญชัย ลีภักดิ์ปรีดา จากสถาบันเทคโนโลยีนานาชาติสิรินธร
9. ศ.ดร.ศรัทธา อาภรณ์รัตน์ จากสถาบันเทคโนโลยีนานาชาติสิรินธร

ประเภท Single recent year data (คิดเฉพาะผลงานปี ค.ศ. 2022)
1. ศ.ดร.ศากุน บุญอิต จากคณะพาณิชยศาสตร์และการบัญชี
2. ศ.นพ.อนุชา อภิสารธนรักษ์ จากคณะแพทยศาสตร์
3. ศ.ดร.ภญ.อรุณพร อิฐรัตน์ จากคณะแพทยศาสตร์
4. ศ.ดร.ผดุงศักดิ์ รัตนเดโช จากคณะวิศวกรรมศาสตร์
5. ผศ.ดร.สุรภาพ แก้วสวัสดิ์วงศ์ จากคณะวิศวกรรมศาสตร์
6. รศ.ดร.วุฒิพล สินธุนาวารัตน์ จากคณะวิทยาศาสตร์และเทคโนโลยี
7. รศ.ดร.ศรุต อำมาตย์โยธิน จากคณะวิทยาศาสตร์และเทคโนโลยี
8. Prof. Dr. Sandhya Babel จากสถาบันเทคโนโลยีนานาชาติสิรินธร
9. ศ.ดร.เกศรา ณ บางช้าง จากวิทยาลัยแพทยศาสตร์นานาชาติจุฬาภรณ์
มหาวิทยาลัยธรรมศาสตร์ ขอแสดงความยินดีกับคณาจารย์ทุกท่านที่ได้รับการจัดอันดับใน World’s Top 2% Scientists ปี 2023
อ้างอิงจาก https://elsevier.digitalcommonsdata.com/datasets/btchxktzyw/6